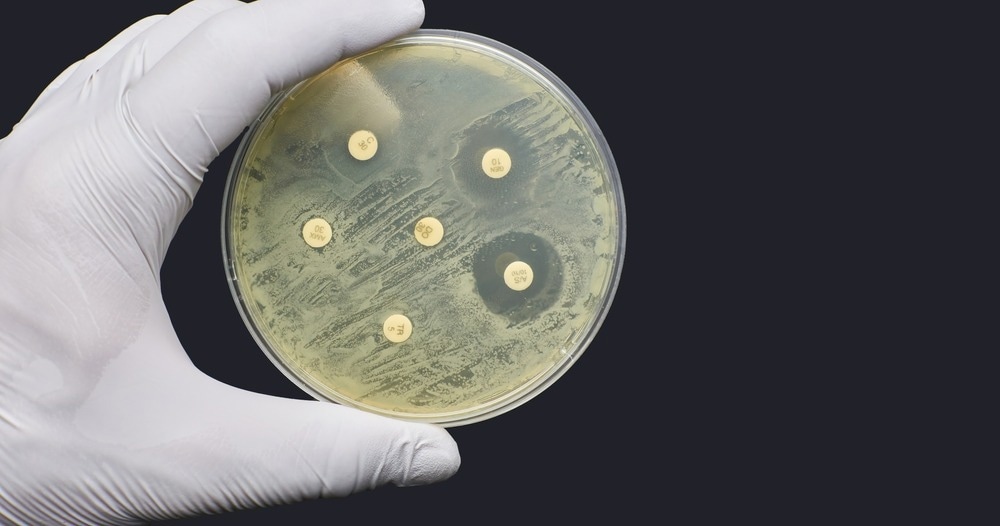
Study: COVID-19 Reverses Progress in Fight Against Antimicrobial Resistance in U.S. Image Credit: MD_style/Shutterstock

In a recent study published in the report from the Centers for Disease Control and Prevention (CDC), researchers assessed the impact of coronavirus disease 2019 (COVID-19) on antimicrobial resistance (AR).
Study: COVID-19 Reverses Progress in Fight Against Antimicrobial Resistance in U.S. Image Credit: MD_style/Shutterstock
Study: COVID-19 Reverses Progress in Fight Against Antimicrobial Resistance in U.S. Image Credit: MD_style/Shutterstock
Background
The COVID-19 pandemic has adversely affected the progress made thus far against AR in the US. Various reports have shown that the hazard of antimicrobial-resistant infections has worsened since the first year of the COVID-19 pandemic, with a 15% increase observed in resistant hospital-onset infections and mortalities.
About the study and results
In the present study, the CDC assessed the condition of antimicrobial resistance in the US after the peaks of COVID-19 infections observed in 2020.
The study results showed that immediately after the COVID-19 infections reached their peaks in 2020, there was a significant increase in the number of resistant infections diagnosed during hospitalization. Notably, there was an overall 15% increase between 2019 and 2020 in concentrations of seven pathogens, including (1) carbapenem-resistant Acinetobacter, which showed a 78% increase, (2) multidrug-resistant Pseudomonas aeruginosa, which displayed a 32% increase, (3) vancomycin-resistant Enterococcus (VRE) with a 14% increase, and (4) methicillin-resistant Staphylococcus aureus (MRSA) with a 13% increase in the number of infections.
Furthermore, the team noted a 60% increase in Candida auris infections in 2020 with a 26% increase in the number of infected diagnosed during hospitalization. Interestingly, a 2019 report revealed that the number of antimicrobial-resistant infections declined by 27% between 2012 and 2017, indicating a steady reduction in antimicrobial-resistant infections until the COVID-19 pandemic began. However, the team noted that Clostridioides difficile was the only pathogen that had a reduction in the number of infections in 2020, possibly due to the alterations made in healthcare-seeking behavior during the pandemic.
The hospitals in the US also displayed a substantial increase in the use of antibiotics and difficulty in following recommended guidance for infection prevention and control. Throughout the pandemic, hospitals reported challenges concerning personal protective equipment (PPE) supply, longer patient stays, and staffing shortages. Hospitals also reported the admission of sicker individuals who needed more frequent as well as longer usage of medical devices such as ventilators and catheters. Hence, the pandemic likely affected the increase in antimicrobial-resistant infections.
Among the 29,400 people who succumbed to antimicrobial-resistant infections in the first year of the pandemic, almost 40% were infected while they were hospitalized. Furthermore, the team noted that between March and October 2020, approximately 80% of patients hospitalized due to COVID-19 were treated with an antibiotic. Such a high number of patients being prescribed antibiotics could put these individuals at risk of side effects, thus creating a pathway for antimicrobial resistance.
Conclusion
To address the threat of increasing antimicrobial-resistant infections, the CDC plans to explore opportunities for development in the following areas:
- Data systems and sharing require expansion of automation of electronic data to allow access to crucial information related to the use of antibiotics and related antimicrobial resistance to healthcare facilities as well as systems;
- Infection control can be enhanced with the continuous availability of high-quality training for infection prevention and control to every healthcare professional as well as healthcare facilities;
- Optimal usage and access to antibiotics and antifungals across all healthcare facilities is also crucial;
- Collection of antimicrobial resistance data obtained from wastewater treatment plans as well as healthcare facilities could be utilized to study the resistance within a community, and wastewater samples from hospitals; and
- Boosting the developmental efforts for novel antifungals, antibiotics, and therapeutics to delay the spread of resistance and lower antibiotic use.